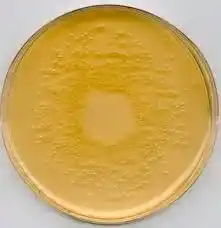

محیط کشت استامید نوترینت براث
محیط کشت استامید نوترینت براث کد 00185 یک محیط مایع تخصصی و افتراقی است که بهطور ویژه برای شناسایی و تمایز برخی باکتریهای گرم منفی، بهخصوص گونههای سودوموناس طراحی شده است.
ویژگی متمایز این محیط، استفاده از استامید بهعنوان تنها منبع نیتروژن و کربن قابل استفاده برای رشد میکروارگانیسمهاست. این ساختار باعث میشود تنها باکتریهایی که توانایی متابولیسم استامید را دارند، قادر به رشد و تغییر محیط باشند.
در این محیط، باکتریهای هدف از طریق آنزیمهای اختصاصی خود استامید را تجزیه کرده و آمونیاک آزاد میکنند. این فرآیند موجب افزایش pH محیط شده و تغییر رنگ شاخص pH را بهدنبال دارد که بهعنوان نشانه مثبت رشد و فعالیت متابولیکی تلقی میشود.
همین واکنش ساده اما دقیق، محیط استامید نوترینت براث را به ابزاری ارزشمند در آزمایشگاههای تشخیص طبی، میکروبیولوژی بالینی، کنترل کیفیت صنایع و تحقیقات دانشگاهی تبدیل کرده است.
از آنجا که بسیاری از باکتریها توانایی استفاده از استامید را ندارند، این محیط نقش مهمی در افتراق سریع و قابل اعتماد ایفا میکند. سهولت استفاده، تفسیر واضح نتایج و دقت بالا از دلایل محبوبیت این محیط در شناسایی باکتریهای خاص محسوب میشود.

در شرکت دانش پژوهان شیمی، اصالت و کیفیت کالا برای ما در اولویت است. شما میتوانید محیط کشت استامید نوترینت براث را می توانید از برند معتبر Merck / Sigma را همراه با برگه آنالیز (COA)، بستهبندی استاندارد و مشاوره علمی تخصصی دریافت کنید.
📌 این محصول با کد 00185 آماده عرضه میباشد.
برای ثبت سفارش و دریافت قیمت روز، با کارشناسان ما تماس بگیرید:
-
☎️ تلفن: 02166859220(ساعات پاسخگویی: 8:30 تا 18:00)
-
📱 واتساپ: 09129618292 (پشتیبانی 24 ساعته)
دانشجویان، پژوهشگران و فعالان حوزه تحقیقاتی میتوانند با اطمینان خاطر، این ماده شیمیایی را از دانش پژوهان شیمی تهیه کنند و پروژههای آزمایشگاهی خود را با کیفیت و دقت بیشتری پیش ببرند.
محیط کشت استامید نوترینت براث
در علوم میکروبیولوژی، شناسایی دقیق باکتریها اهمیت حیاتی دارد؛ زیرا تشخیص نادرست میتواند منجر به خطاهای درمانی، آلودگی صنعتی یا نتایج تحقیقاتی غیرقابل اعتماد شود.
محیطهای کشت افتراقی مانند استامید نوترینت براث با هدف سادهسازی و تسریع فرآیند شناسایی طراحی شدهاند. این محیط بهگونهای فرمولبندی شده که تنها میکروارگانیسمهایی با توانایی متابولیسم خاص بتوانند در آن فعال باشند.
محیط کشت استامید نوترینت براث با تمرکز بر واکنش متابولیکی استامید، امکان تشخیص دقیق باکتریهایی مانند Pseudomonas aeruginosa را فراهم میکند.
این باکتری در بسیاری از عفونتهای بیمارستانی، آلودگیهای محیطی و صنایع غذایی نقش دارد و شناسایی سریع آن اهمیت بالایی دارد. استفاده از این محیط باعث کاهش نیاز به تستهای پیچیده و زمانبر میشود.
در این مقاله، ساختار محیط، خواص فیزیکوشیمیایی، مکانیسم عملکرد، ویژگیها، کاربردهای اصلی، مزایا، محدودیتها، خطرات ایمنی و سوالات متداول بهصورت جامع بررسی میشود تا راهنمایی کامل برای دانشجویان، کارشناسان آزمایشگاه و پژوهشگران فراهم گردد.
- کد: 00185
- نام انگلیسی: Acetamide Nutrient Broth
- suitable for microbiology, NutriSelect® Basic
- MDL number: MFCD00239573
- UNSPSC Code: 41171607
- NACRES: NA.85
- بسته بندی: 500G
شرکت دانش پژوهان شیمی واردکننده اصلی مواد شیمیایی آزمایشگاهی بخصوص برند مرک آلمان و سیگماآلدریچ در ایران می باشد. جهت خرید محیط کشت می توانید با همکاران این مجموعه تماس حاصل نمائید.
محیط کشت استامید نوترینت براث کد 00185 یکی از محصولات تولیدی شرکت مرک merck می باشد. این شرکت یکی از بزرگترین کمپانی های تولیدی مواد شیمیایی آزمایشگاهی در جهان می باشد که در بین محققین و دانشمندان و… از جایگاه ویژه ای برخوردار است.
ساختار و ترکیبات محیط کشت استامید نوترینت براث
🧬 اجزای اصلی محیط استامید نوترینت براث:
• استامید (منبع اختصاصی نیتروژن و کربن)
• نمکهای معدنی ضروری
• بافرهای پایدارکننده pH
• شاخص pH حساس به قلیایی شدن
• آب مقطر استریل
🔹 نقش اجزا
استامید: تنها منبع غذایی قابل مصرف
نمکها: حفظ تعادل اسمزی
شاخص pH: نمایش بصری نتیجه تست
بافرها: جلوگیری از نوسانات ناخواسته
⚗️ خواص و اقدامات فیزیکوشیمیایی
🌡 دمای انکوباسیون: 35–37 درجه سانتیگراد
🧪 حالت فیزیکی: مایع شفاف
🎨 تغییر رنگ: زرد → صورتی یا قرمز
⚖️ pH اولیه: حدود 6.8
⏱ زمان مشاهده نتیجه: 24 تا 48 ساعت

مکانیسم عملکرد محیط کشت استامید نوترینت براث
استامید توسط آنزیمهای باکتری تجزیه میشود → آمونیاک آزاد میگردد → pH افزایش مییابد → تغییر رنگ شاخص pH رخ میدهد.
✨ ویژگیهای کلیدی محیط
⭐ اختصاصی بودن
تنها باکتریهای خاص قادر به رشد هستند.
⭐ وضوح نتایج
تغییر رنگ واضح، تفسیر را آسان میکند.
⭐ کاهش خطای تشخیصی
افتراق دقیق بین گونههای مشابه.
⭐ سرعت بالا
نتیجهگیری در زمان کوتاه.
⭐ سازگاری با تستهای تکمیلی
امکان استفاده همزمان با سایر آزمونها.
دعوت ویژه برای بازدید از محصولات و مقالات ما
از شما دعوت میکنیم برای آشنایی بیشتر با محصولات آزمایشگاهی و مقالات تخصصی ما، سری به وبسایت بزنید و سایر محصولات از جمله محیط کشت روگوسا آگار را مشاهده کنید. هدف ما این است که فرآیند خرید شما سریعتر، آسانتر و با اطمینان کامل انجام شود.
همین حالا روی لینک زیر کلیک کنید و از محتوای آموزشی و محصولات متنوع ما دیدن کنید:
کاربرد اصلی محیط کشت استامید نوترینت براث
1️⃣ شناسایی سودوموناس آئروژینوزا
این محیط یکی از تستهای کلیدی برای تأیید هویت این باکتری بیماریزا است.
2️⃣ افتراق باکتریهای گرم منفی
کمک به جداسازی سودوموناس از انتروباکتریاسهها.
3️⃣ کاربرد در آزمایشگاههای تشخیص طبی
برای بررسی نمونههای بالینی مانند ترشحات، ادرار و زخمها.
4️⃣ کنترل کیفیت در صنایع دارویی
بررسی آلودگی میکروبی در مواد اولیه و خطوط تولید.
5️⃣ پایش بهداشت محیط
استفاده در نمونههای آب، سطوح و تجهیزات.
6️⃣ آموزش دانشجویان میکروبیولوژی
آموزش مفاهیم متابولیسم افتراقی با نتایج قابل مشاهده.
7️⃣ تحقیقات میکروبی
مطالعه مسیرهای آنزیمی و متابولیسم نیتروژن.
8️⃣ بررسی توان متابولیکی باکتریها
ارزیابی فعالیت آنزیمهای تجزیهکننده استامید.
ارتباط مستقیم با آنزیمهای اختصاصی باکتری
نکتهای که کمتر به آن اشاره میشود این است که نتیجه مثبت در استامید نوترینت براث وابسته به وجود آنزیم acylamidase در باکتری است.
این آنزیم مسئول شکستن پیوند آمیدی در استامید و آزادسازی آمونیاک است.
استامید → (آنزیم acylamidase) → آمونیاک + اسید
🔹 بنابراین:
رشد باکتری بدون تغییر رنگ = منفی
تغییر رنگ بدون کدورت = واکنش ناقص
کدورت + تغییر رنگ = واکنش مثبت واقعی

شرایط خرید محیط کشت استامید نوترینت براث کد 00185 از دانشپژوهان شیمی
برای محیط کشت استامید نوترینت براث کد 00185 مرک از سایت رسمی دانشپژوهان شیمی، کافیست مراحل ساده زیر را دنبال کنید:
🔹 استاندارد بستهبندی و ایمنی:
این محصول باید در ظروف مقاوم، دربسته و عایق رطوبت بستهبندی شود تا خواص آن در حین حملونقل و نگهداری دچار تغییر نشود.
🔹 تأمین از برندهای معتبر:
ما این ماده را تنها از برندهای مطرحی مانند Merck (مرک) و Sigma-Aldrich (سیگما آلدریچ) تأمین میکنیم تا بالاترین خلوص و کیفیت برای شما تضمین شود.
🔹 مناسب برای مصرف آزمایشگاهی و صنعتی:
در صورت نیاز به خرید جزئی یا عمده، کارشناسان ما آماده ارائه مشاوره علمی و فنی پیش از خرید هستند.
📦 موجودی در بستهبندیهای متنوع
قابل ارائه در بسته بندی: 500 گرمی با ارسال سریع به سراسر کشور.
📞 ثبت سفارش و دریافت مشاوره تخصصی:
برای ثبت سفارش یا دریافت قیمت بهروز، با ما تماس بگیرید یا فرم سفارش را از طریق وبسایت تکمیل کنید.
تلفن: [02166859216 – 02166859220 – 09129618292]
ایمیل: [info@daneshpazhoohaneshimi.com]
سایت: [www.daneshpazhoohaneshimi.com]
🎯 همین حالا اقدام کنید!
محیط کشت استامید نوترینت براث کد 00185 خالص و آزمایشگاهی را با شرایط ویژه از تأمینکننده معتبر دریافت نمایید.
خرید محیط کشت استامید نوترینت براث
شرکت دانش پژوهان شیمی که نمایندگی مرک آلمان و نمایندگی سیگماآلدریچ در ایران، با همکاری کارشناسان مجرب خود در بخش فنی و فروش، جهت تامین مواد اولیه پژوهش های تحقیقاتی ماده های با کیفیت بالا و قیمت مناسب را فراهم نموده است. شما می توانید جهت خرید محیط کشت استامید نوترینت براث با بخش فروش شرکت دانش پژوهان شیمی تماس حاصل بفرمایید و پس از دریافت پیش فاکتور و اطمینان حاصل نمودن از صحت نام محصول، کد، شماره CAS نامبر مواد شیمیایی درخواستی اقدام به ثبت سفارش نمایید تحویل کالاهای خریداری شده و زمان تحویل آنها به صورت زیر می باشد.
- زمان ارسال سفارشات از انبار: ۲۴ تا ۴۸ ساعت کاری می باشد
- نحوه ارسال کالای مشتریان: تهران توسط پیک
- ارسال شهرستان: توسط شرکت های حمل و نقل ( ترمینال، پست، تیپاکس)
تفسیر ظریفتر تغییر رنگ محیط کشت استامید نوترینت براث
برخلاف تصور عمومی، شدت رنگ اهمیت دارد:
🟡 زرد باقیمانده → منفی
🌸 صورتی کمرنگ → واکنش ضعیف یا مرزی
🔴 صورتی پررنگ یا قرمز → مثبت قطعی
📌 این تفاوت رنگها در تشخیص بین گونههای نزدیک سودوموناس بسیار مهم است.
⏳ وابستگی نتیجه به زمان انکوباسیون
یکی از خطاهای رایج این است که نتیجه خیلی زود یا خیلی دیر خوانده میشود.
⏱ زمان ایدهآل خواندن نتیجه: 24 تا 36 ساعت
کمتر از 24 ساعت → احتمال منفی کاذب
بیشتر از 48 ساعت → احتمال قلیایی شدن غیر اختصاصی
📍 پس زمانسنجی دقیق در این محیط حیاتی است.
حساسیت بالا به شرایط محیطی
محیط استامید نوترینت براث نسبت به چند عامل بسیار حساس است:
دمای پایین → کاهش فعالیت آنزیمی
دمای بالا → تخریب شاخص pH
نور مستقیم → تغییر تدریجی رنگ
درپوش شل → تبخیر و خطای pH
🧪 به همین دلیل در آزمایشگاههای حرفهای، این محیط همیشه تازه آماده یا تازه مصرف میشود.
تفاوت استامید نوترینت براث با محیطهای مشابه
🆚 نوترینت براث معمولی
نوترینت براث: رشد عمومی
استامید براث: رشد + افتراق متابولیک
🆚 سیترات
سیترات: مصرف منبع کربن
استامید: مصرف منبع نیتروژن + کربن
📌 استامید براث اختصاصیتر و محدودتر است اما دقت بالاتری دارد.

نقش این محیط در کاهش تستهای اضافی
استفاده درست از استامید نوترینت براث میتواند:
تعداد تستهای بیوشیمیایی اضافی را کم کند
زمان شناسایی نهایی را کوتاه کند
هزینه مصرف کیتها را کاهش دهد
به همین دلیل در آزمایشگاههای پرتعداد، از نظر اقتصادی هم محیط مهمی محسوب میشود.
مزایا و معایب محیط کشت استامید نوترینت براث
✅ مزایا
- اختصاصیت بالا
- تفسیر آسان نتایج
- عدم نیاز به تجهیزات پیچیده
- مناسب برای روتین آزمایشگاهی
- کاهش زمان تشخیص
❌ معایب
- محدود به باکتریهای خاص
- عدم کاربرد برای طیف وسیع میکروارگانیسمها
- نیاز به رعایت دقیق شرایط انکوباسیون
☣️ خطرات و نکات ایمنی محیط کشت استامید نوترینت براث
⚠️ احتمال رشد باکتریهای بیماریزا
⚠️ تماس مستقیم با محیط ممنوع
⚠️ استفاده از دستکش و روپوش الزامی
⚠️ دفع محیط مصرفشده طبق اصول پسماند بیولوژیک
⚠️ عدم استنشاق یا تماس چشمی
❓ سوالات متداول محیط کشت استامید نوترینت براث
🔹 این محیط برای چه باکتریهایی مناسب است؟
بیشتر برای سودوموناسها، بهویژه P. aeruginosa.
🔹 تغییر رنگ به چه معناست؟
نشاندهنده متابولیسم استامید و نتیجه مثبت تست است.
🔹 آیا به محیط مکمل نیاز دارد؟
خیر، بهصورت آماده استفاده میشود.
🔹 آیا برای تست قطعی کافی است؟
بهتر است همراه تستهای تکمیلی استفاده شود.
🔹 شرایط نگهداری چگونه است؟
در جای خنک، خشک و دور از نور مستقیم.
جایگاه این محیط در الگوریتم شناسایی باکتریها
محیط کشت استامید نوترینت براث معمولاً در مرحله تأیید نهایی شناسایی استفاده میشود، نه در غربالگری اولیه. یعنی زمانی که بر اساس تستهای اولیه (مانند اکسیداز مثبت، رشد هوازی، شکل کلنی) احتمال سودوموناس مطرح شده، این محیط بهعنوان تست تأییدی متابولیک وارد عمل میشود.
📌 به زبان ساده:
این محیط بیشتر نقش «قاضی نهایی» را دارد تا «غربالگر اولیه».
رفتار باکتریهای غیرهدف در این محیط
نکته جالب این است که برخی باکتریها:
زنده میمانند
ولی نه رشد مؤثر دارند و نه تغییر رنگ ایجاد میکنند
این ویژگی باعث میشود:
✔️ مثبت کاذب نداشته باشیم
✔️ محیط همچنان اختصاصی باقی بماند

نکات نگهداری حرفهای محیط کشت استامید نوترینت براث
📍 دمای نگهداری: 2–8°C
📍 دور از نور مستقیم
📍 درب کاملاً بسته
📍 عدم فریز شدن
📍 عدم استفاده پس از تغییر رنگ اولیه
⚠️ اگر محیط قبل از کشت، تهرنگ صورتی داشته باشد → غیرقابل مصرف است
🧠 کاربرد غیرمستقیم اما مهم
در برخی آزمایشگاهها، از این محیط برای:
- بررسی سلامت مسیر متابولیسم نیتروژن
- مقایسه سویههای جهشیافته
- بررسی اثر مواد مهارکننده آنزیمها
- استفاده تحقیقاتی میشود، نه صرفاً تشخیصی.
🧩 جایگاه در استانداردهای آموزشی
این محیط یکی از محیطهای کلاسیک آموزشی برای آموزش مفاهیم زیر است:
- متابولیسم افتراقی
- آنزیمهای اختصاصی
- تفسیر رنگ شاخصها
- خطاهای تشخیصی وابسته به زمان
- به همین دلیل در آموزش عملی بسیار محبوب است.
⚠️ خطاهای رایج که باید حتماً از آنها پرهیز شود
❌ تلقیح بیشازحد
❌ خواندن نتیجه بعد از 72 ساعت
❌ استفاده از کلنیهای پیر
❌ مخلوط کردن با تستهای اسیدی
❌ نگهداری در دمای اتاق طولانیمدت
قیمت فروش محیط کشت استامید نوترینت براث
شرکت دانش پژوهان شیمی یکی از بزرگترین وارد کنندگان و فروشندگان مواد شیمیایی، آزمایشگاهی بخصوص فروش محیط کشت استامید نوترینت براث کد 00185 که از محصولات نمایندگی مرک آلمان می باشد. این شرکت در زمینه واردات محصولات از تجربه بسیار بالایی برخوردار است. شما می توانید جهت تهیه این محصولات (اصلی) با بخش فروش شرکت تماس گرفته و با کارشناسان این شرکت در ارتباط باشید. از طریق کانال واتساپ شرکت نام محصول به همراه میزان نیاز خود را ارسال تا در کمترین زمان پاسخ استعلام خود را دریافت نمائید. امیدواریم بتوانیم با ارائه محصولات اصلی و با بهترین کیفیت شما را برای رسیدن به اهدافتان یاری نمائیم.
جهت محصولات بیشتر واستعلام سریع قیمت محیط کشت استامید نوترینت براث کد 00185 میتوانید از طریق کانال واتساپ شرکت با ارسال نام ماده و مقدار نیاز در کمترین زمان پاسخ استعلام خود را دریافت نمائید.
راههای ارتباطی
شماره های تماس:
021-66859216
021-66859220 (ساعات تماس:8.30 الی 19)
واتساپ:09129618292 (24ساعت)
Last Updated on 12/14/2025 by adminm


